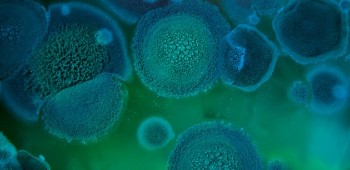

Personal injury
As an RCN member you’re eligible for legal advice and representation for injuries sustained due to the fault of someone else. Whether a workplace injury or not, we can help you obtain 100% of your compensation. The service is completely free to members, regardless of whether the claim is successful.
We can also help your family and friends if they’ve suffered injury through no fault of their own.
Personal injury claims for RCN members
Accidents happen every day and a serious injury could be life changing. People depend on their wellbeing to provide for their families, support their lifestyle and secure the future of their loved ones.
If you’ve been injured in an accident or incident that wasn’t your fault, then you shouldn’t have to suffer the costs. As part of your membership we can help you claim compensation for your injuries, medical expenses, and loss of income whatever the cause or nature of your accident.
You will need legal advice if you are considering making a claim and it is vital that you access advice as soon as possible after the incident. You have three years from the date of the injury/accident to begin court proceedings. If you are making a claim for work related stress, you have three years from the date that the stress began. Please be aware it can take six months of preparatory work before a solicitor can start court proceedings on your behalf. It is important to seek advice as soon as possible after the incident to ensure there is sufficient time to prepare your case before the deadline. Find out more about making a claim below and contact us without delay.
Alongside progressing your claim, we can also offer members emotional support and counselling to help during this difficult time. Find out more about our member support services here.Personal injury claims for friends and family
Do you have friends or family who have been injured through the fault or negligence of another and wish to make a claim for compensation? We can also provide them with expert tailored legal advice, assistance and representation to bring a claim.
Claims will be underwritten by a highly competitive after the event insurance policy, meaning your loved ones will have peace of mind that they will receive at least 75% of the compensation awarded.
You will also have peace of mind that they are receiving a quality service and one which gives back to the RCN, as any profits made (as a result of costs being paid by the defendant in the case) will come back to the RCN to further support its members.
Eligibility
- The claim must be in excess of the Small Claims Limit as set by the Courts (£1,500 for non-road traffic accidents and £5,000 for claims arising out of road traffic accidents in England and Wales)
- The prospects of success must be at least 51%
- The injury must have occurred within the past three years
- For membership cover, members must have been in membership at the time of the incident (n.b. members not in membership at the time of the incident can use the Friends and Family service instead)
Personal injury claims are supported by RCNLaw. RCNLaw is an Alternative Business Structure. The information you provide will be stored by the RCN and shared with RCNLaw, who will also retain your information.
Road traffic accidents happen every day, many of which result in injuries to the driver and/or passenger(s), ranging from whiplash and broken bones to serious head and spinal injuries.
Our expert team have a wealth of experience in road traffic accident claims, ensuring you are fully compensated for:
- Injuries sustained;
- Loss of income;
- Medical expenses;
- Rehabilitation.
Please see our section above on eligibility for road traffic accidents.
If you’ve been injured in a road traffic accident that wasn’t your fault, contact our team of personal injury specialists who are dedicated to getting the best results for you.
Tip: Before you purchase (or when renewing) your car insurance with any provider, check if you are paying extra for a BTE (Before The Event) legal cover product. It may be that you can save money by utilising the RCN’s personal injury claims service provided by RCNLaw (subject to small claims limits and being in membership at the time of the accident).
All employers have a duty of care to protect their employees against injury or accidents at work.
Some of the most common injuries in the workplace results from:
- Slips or trips;
- Falls from a height;
- Heavy lifting;
- Defective equipment.
Owners have a duty of care to ensure their premises are in a reasonable, safe condition to prevent injuries, however accidents in public places are common.
Our personal injury team deal with a range of public liability claims such as:
- Slips or trips in restaurants, supermarkets, shopping centres and car parks;
- Falls resulting from defective pavements, untreated ice or potholes;
- Injuries following beauty treatments.
If you have been a victim of crime which has resulted in injury, our professional team can expertly and patiently guide you through the process of claiming for compensation.
Alongside progressing your claim, we can also offer you support and counselling to help during this difficult time.We have dealt with a number of workplace illness and disease claims such as:
- Work related cancer;
- Asbestos related illnesses;
- Noise injuries;
- Vibration injuries.
Friends or family who sustained their injury in England should complete this online form or call 0333 2341 372. Your case will be handled by RCNLaw.
Members who sustained their injury whilst at work in Northern Ireland should contact us for further advice and onwards referral to our specialist team. Your case will be handled by your RCN regional office.
The friends and family service is not available in Northern Ireland.
Members who sustained their injury in Scotland (whether at work or otherwise) should contact us for further advice and onwards referral to our specialist team. Your case will be handled by your RCN regional office.
Friends or family who sustained their injury in Scotland should complete this online form. You case will be handled by Anderson Strathern.
Friends or family who sustained their injury in Wales should complete this online form or call 0333 2341 372. Your case will be handled by RCNLaw.
Members who sustained their injury whilst at work in the Channel Islands or Isle of Man should contact us for further advice and onwards referral to our specialist team. Your case will be handled by your RCN regional office.
The friends and family service is not available in the Channel Islands or Isle of Man.
Hear from Heather
Other support available
Alongside processing your claim, we can also offer RCN members emotional support and counselling to help during difficult times. Find out more about our member support services here.
You can access our extensive advice about personal injury and accidents at work here including practical steps to take in the aftermath of an injury.Personal injury claims support is provided by:

